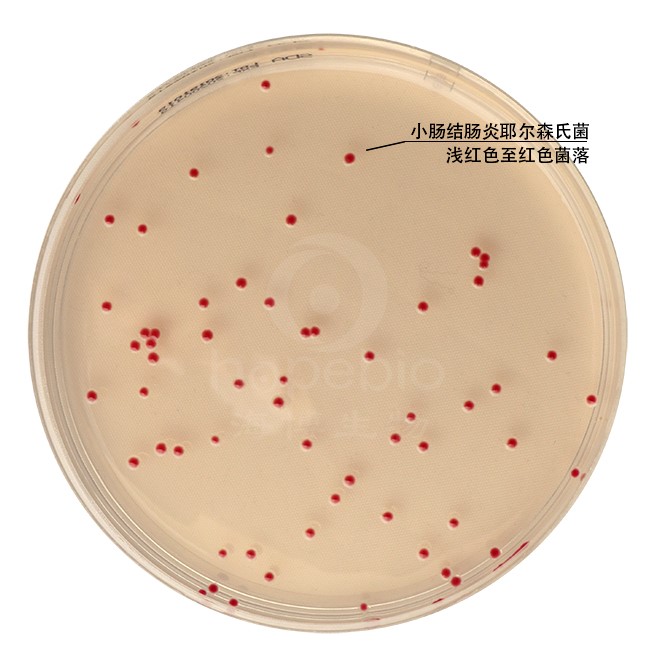

海博微信公众号
海博天猫旗舰店




一、用途及原理
此培养基主要用于乳制品中嗜冷菌计数。
蛋白胨、酵母浸粉提供细菌生长所需的碳源、碳源及维生素,少量的葡萄糖可提供碳源促进细菌的快速生长,结晶紫可抑制一些非专性嗜冷的革兰氏阳性菌的生长,TTC为显色剂,细菌生长时可将TTC还原,菌落呈红色,琼脂为凝固剂。
二、培养基配方(g/L)
|
胰蛋白胨 |
5.0 |
|
酵母浸粉 |
2.5 |
|
葡萄糖 |
1.0 |
|
结晶紫 |
0.001 |
|
TTC |
0.05 |
|
琼脂 |
15 |
|
pH |
7.1±0.2 |
三、配制方法
称取本品23.5,加热溶解于1000mL蒸馏水中,121℃灭菌15min,冷却至50℃左右,倾入无菌平皿备用。
四、生长现象及结果观察
接种以下质控菌株,在20-25℃下培养48-72小时:
|
质控菌株 |
菌株编号 |
接种量/CFU |
生长现象 |
|
小肠结肠炎耶尔森氏菌 |
ATCC23715 |
20-200 |
红色菌落 |
相关产品:
注:本文属海博生物原创,未经允许不得转载。
上一篇:CAMHB肉汤的试验方法与现象
下一篇:血液琼脂基础原理及实验现象
| 相关文章: | |
| 丙型肝炎病毒(HCV)简介 | |
